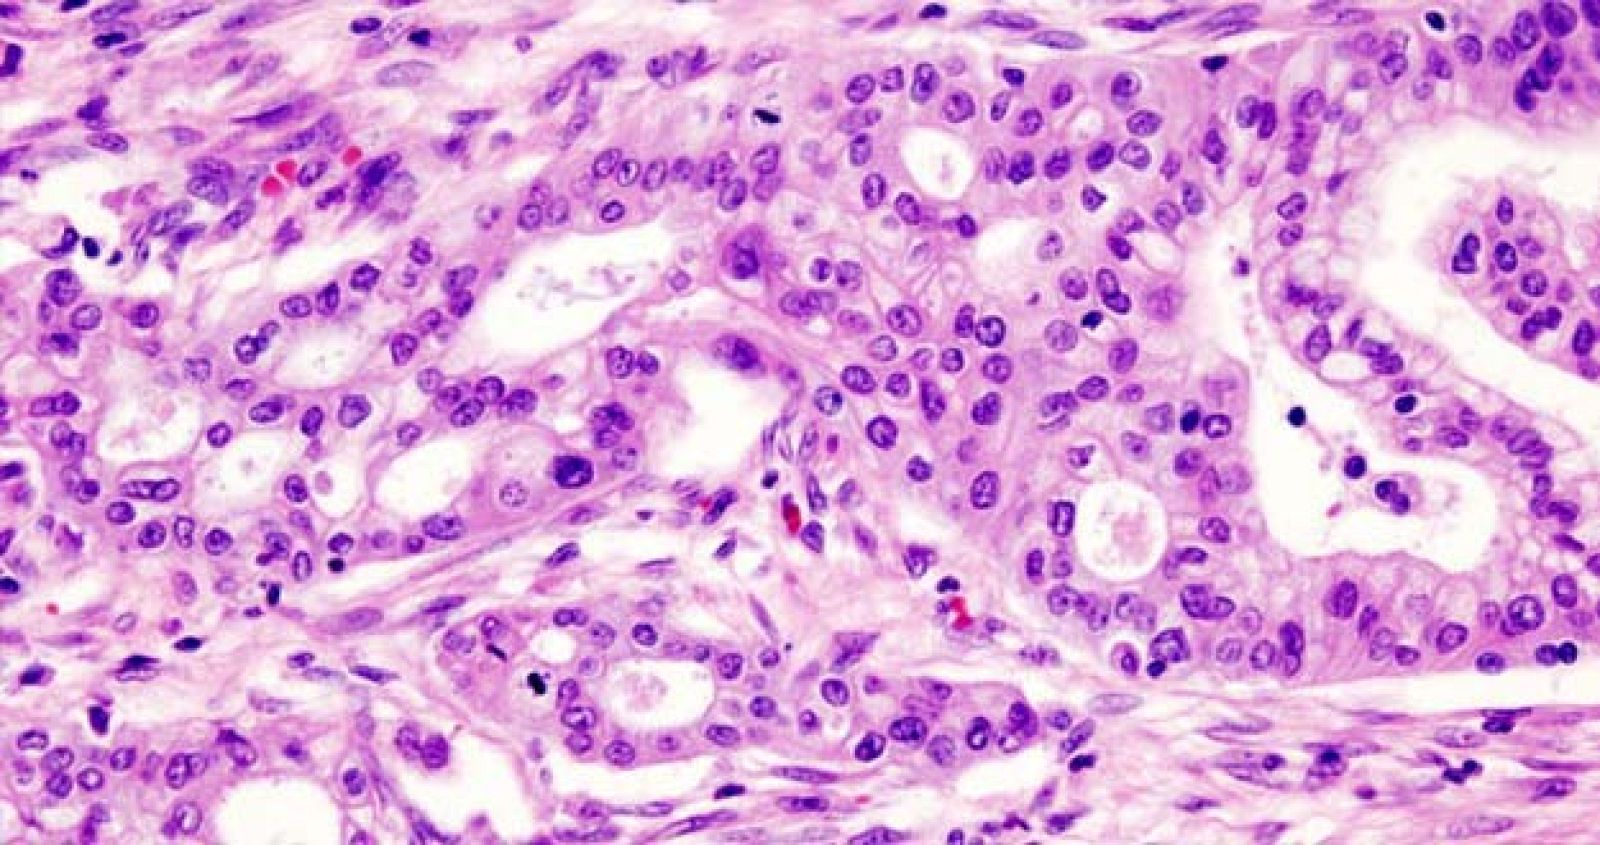
Imagen de un adenocarcinoma de páncreas.

El CNIO descubre unas células brillantes responsables del desarrollo de los tumores
- Tienen una fluorescencia verde fruto de una vitamina
- El marcador identifica las células madre tumorales más invasivas
- La luminosidad puede permitir el desarrollo de nuevos fármacos

Investigadores del Centro Nacional de Investigaciones Oncológicas (CNIO) han descubierto y caracterizado un nuevo marcador específico de las células madre cancerígenas: la riboflavina o vitamina B2, un pigmento que emite fluorescencia verde como resultado de su acumulación en vesículas intracelulares.
Esta propiedad luminosa sirve para su rastreo, aislamiento y posterior purificación sin la necesidad de utilizar anticuerpos u otras técnicas más complejas y de mayor coste económico.
Los resultados de la investigación, liderada por los científicos Irene Miranda, Bruno Sainz y Christopher Heeschen, se publican este domingo en la revista Nature Methods.
“El descubrimiento de este nuevo marcador supone un gran avance ya que identifica a las células madre tumorales que son las más invasivas y quimioresistentes. La autofluorescencia de estas células permitirá rastrearlas de una forma fácil, sencilla y barata, así como estudiar el origen de la quimioresistencia de los tumores”, indica Irene Miranda, primera firmante del artículo.
“Normalmente solo vemos las hojas del árbol que representan los tumores y no podemos divisar las raíces, que son las auténticas responsables de su progresión y crecimiento”, ilustra Miranda.
Células que brillan por una vitamina
Los tumores son mosaicos de células muy distintas morfológica y molecularmente. En esta heterogeneidad celular, se calcula que un 1-2% de la totalidad de la masa tumoral está compuesta por las células madre tumorales, señaladas en los últimos años como las responsables del origen del cáncer y de la resistencia a las quimioterapias convencionales.
Este porcentaje tan pequeño dificulta su aislamiento y análisis, así como el estudio del origen de las resistencias a fármacos.
Sin embargo, los investigadores han descubierto que las células madre tumorales acumulan vitamina B2 debido a un aumento de la proteína ABCG2, responsable del transporte de la vitamina hacia el interior de las vesículas intracelulares que confieren luminosidad a las células. El porqué de este fenómeno está todavía por determinar.
El hallazgo se ha realizado en varios tipos de tumores, incluidas muestras de pacientes de cáncer de páncreas, hígado, colon y pulmón.
Utilidad de las células luminosas
Pese a las incógnitas sobre su naturaleza, la autofluorescencia podría impulsar la medicina personalizada del futuro y el desarrollo de tratamientos oncológicos más eficaces.
“A partir de ahora podremos aislar las células autofluorescentes procedentes de una biopsia y testar su sensibilidad en un panel de medicamentos experimentales o ya comercializados”, afirman Sainz y Heeschen.
“De este modo queremos acelerar la identificación de nuevos fármacos o combinaciones de ellos que sean capaces de eliminar las células madre cancerígenas de ese paciente en particular”, afirma Sainz.
El estudio ha sido financiado por la Unión Europea, el Instituto de Salud Carlos III, el Ministerio de Economía y Competitividad del Gobierno de España y la Fundación ‘La Caixa’.



